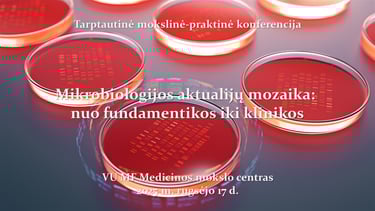

Tarptautinė mokslinė-praktinė konferencija „Mikrobiologijos aktualijų mozaika: nuo fundamentikos iki klinikos“
NAUJIENOSRENGINIAI
Maloniai kviečiame dalyvauti tarptautinėje mokslinėje-praktinėje konferencijoje „Mikrobiologijos aktualijų mozaika: nuo fundamentikos iki klinikos“, kuri vyks 2025 m. rugsėjo 17 d. 9:00–17:35 val. VU MF Medicinos mokslo centro D1-16.1 konferencijų salėje (Žaliųjų ežerų g. 2, Vilnius). Renginys yra nemokamas ir vyks lietuvių bei anglų kalbomis.
Konferencijos metu pirmą kartą Lietuvoje bus pristatyti tyrimų duomenys žmogaus burnos mikrobiomo ir jo sąsajų su sisteminėmis ligomis srityje; pateikti naujų bakterines bioplėveles slopinančių medžiagų tyrimų rezultatai; apžvelgti naujausi duomenys apie mikroorganizmų atsparumą antimikrobinėms medžiagoms bei aptartos galimybės ir priemonės jį valdyti.
Konferencija registruota Higienos instituto Kompetencijų centre ir skirta medicinos gydytojams, infekcinių ligų gydytojams, laboratorinės medicinos gydytojams, klinikiniams farmakologams, gydytojams reumatologams, visų specialybių gydytojams odontologams, burnos higienistams, visuomenės sveikatos specialistams, medicinos biologams, biomedicinos technologams bei mikrobiologams tyrėjams, dirbantiems žmogaus mikrobiomo ir mikroorganizmų atsparumo antimikrobinėms medžiagoms srityse.
Konferencijos organizatoriai: Vilniaus universiteto Medicinos fakultetas, Lietuvos infektologų draugija, Lietuvos mikrobiologų draugija, Lietuvos laboratorinės medicinos draugija, Lietuvos Respublikos odontologų rūmai.
Konferencijos dalyviams bus išduodami 6 val. trukmės Vilniaus universiteto Medicinos fakulteto kvalifikacijos tobulinimo pažymėjimai. Konferencijos pažymėjimai dalyviams ir pranešėjams bus išsiunčiami elektroniniu paštu.
Kontaktas pasiteiravimui: prof. dr. Tomas Kačergius, el. p. tomas.kacergius@mf.vu.lt
Registruotis į renginį galima https://is.mvg.vu.lt/external/login . Registracija vykdoma iki 2025 m. rugsėjo 16 d. Dėl ribotų vietų skaičiaus, organizatoriai pasilieka teisę stabdyti registraciją.
Su konferencijos programa galite susipažinti https://www.mf.vu.lt/images/2_Konferencijos_programa_2025_rugs%C4%97jis_Tomas_Ka%C4%8Dergius.pdf

Lietuvos Mikrobiologų draugija
© 2024 Visos teisės saugomos
